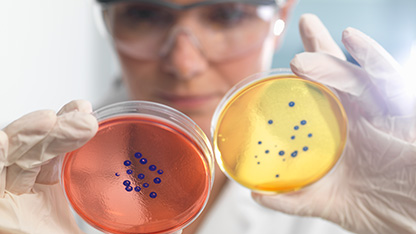
scientist examining samples

Our microbiology services provide microbiological analytical solutions through testing, monitoring and consultancy aiding risk management and ensuring personnel safety in various industries dealing with fuels, chemicals, and waters.
Microbiological life is all around us and can be of both benefit and detriment in many scenarios. The negative impact of microbiological activity presents an ongoing challenge that must be tested, monitored, managed, and mitigated.
To investigate, discuss and address your microbiology needs, you need an experienced, reliable partner to offer world-class knowledge and support in both onshore and offshore environments.

Microbiological Monitoring, Testing & Consultancy
To prevent detrimental microbiological activity on your assets, Intertek provides a wide range of Microbial Monitoring and Microbial Testing solutions for many sectors. These practices help prevent Microbiologically Influenced Corrosion (MIC), Reservoir souring, and many other issues, not only in the Oil & Gas industry but also the future world of energy, including hydrogen transport and storage, and carbon capture utilisation and storage.
To drive forward an energy transition our knowledgeable team of experts also provide bespoke research projects solutions.

Microbiological Test Kits & Consumables
Intertek can supply a range of consumables to sample, analyse and monitor systems to ensure optimal and safe operation. Superior quality Microbiological Media Test Kits provide robust and versatile frontline testing of both of planktonic and sessile samples, while our Sidestream units aid biofilm monitoring strategies.
This range of consumables complements our vast repertoire of microbial and chemical Exploration & Production testing services, and other non-related microbiology testing services.
Water Quality & Hygiene Management
Strict national and international regulations demand reliable testing of potable water supplies to accredited standards and testing methods.
Potable water testing and legionella water management is key to safeguard employee wellbeing and the undertaking of legionella risk assessments is important in all industries.
Our team of experts can offer support services in industrial systems and remote locations, such as, offshore installations and marine vessels.
To enhance water quality, our disinfection and inspections services provide additional confidence.
Informed by decades of experience and independent research and development, we provide a complete range of Total Quality Assurance microbiology solutions designed to comply with legislation and experts present clear, concise explanations of microbiological activity in various environments.
Many of our microbiologists, chemists, hygienists, and engineers are experts in their fields, possessing capabilities in areas such as data analysis, modelling, risk assessments and the development of efficient management programmes. Through years of innovation and the development of new technologies such as applying molecular testing methods, we have established a global reputation for delivering trusted and reliable microbiology services form our centres of excellence and cutting-edge laboratories in over 100 countries.

Intertek Academy UK
- 2 Day Oilfield Microbiology Course
- 1 Day Offshore Legionella Awareness Course
- 1 Day Offshore Legionella Awareness Course for Duty Holders
- 1 Day Offshore Legionella Awareness Course (Short & Refresher)
- 2 Day Offshore Legionella and Water Hygiene Management Course
- Oil in Water Training Course
Learn More: www.intertek.com/training/uk/
Oilfield Microbiology
FACTSHEET
Tracking down pesky bugs in the oilfield
FACTSHEET
Media Testing Kits and Monitoring Solutions
BROCHURE
BROCHURE


